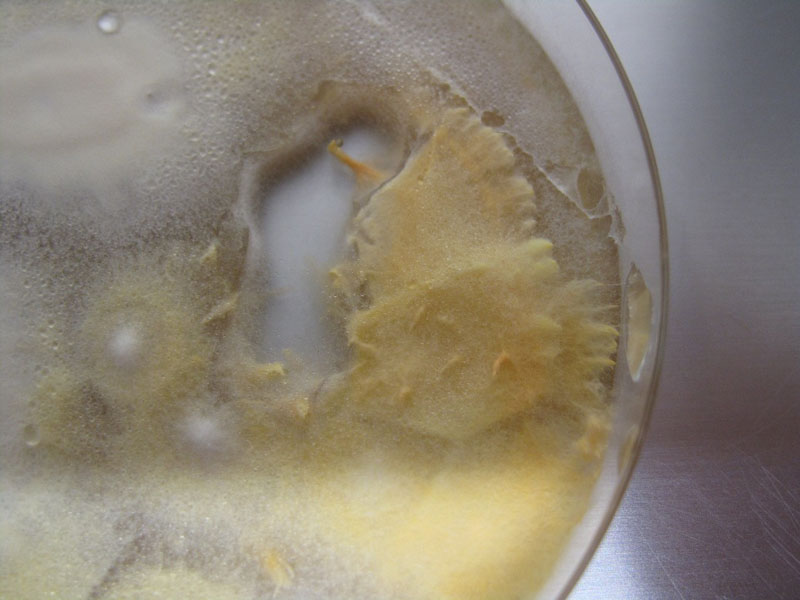

Pilze Pilze Forum Archiv 2010
Noch ein Foto
Geschrieben von: HoBi
Datum: 2. Februar 2010, 19:05 Uhr
Antwort auf: Wer oder was bin ich? :-) (HoBi)
|
Schon interessant, oder??
|
Beiträge in diesem Thread
- Wer oder was bin ich? :-) -- HoBi -- 31. Januar 2010, 15:43 Uhr
- Re: Wer oder was bin ich? :-) -- Andreas -- 31. Januar 2010, 21:27 Uhr
- Re: Wer oder was bin ich? :-) -- Werner2 -- 1. Februar 2010, 17:43 Uhr
- Re: Wer oder was bin ich? :-) -- Andreas -- 1. Februar 2010, 18:07 Uhr
- Re: Wer oder was bin ich? :-) *PIC* -- Werner2 -- 1. Februar 2010, 18:19 Uhr
- Wir sind sprachlos :-)) *oT* -- HoBi -- 2. Februar 2010, 18:26 Uhr
- Kein Indianerregenwurm ;-) -- HoBi -- 2. Februar 2010, 18:12 Uhr
- Re: Kein Indianerregenwurm ;-) -- Werner2 -- 2. Februar 2010, 18:23 Uhr
- Re: Wer oder was bin ich? :-) -- UweL -- 2. Februar 2010, 15:59 Uhr
- Zu 99% ins Schwarze getroffen! -- HoBi -- 2. Februar 2010, 17:55 Uhr
- Noch ein Foto -- HoBi -- 2. Februar 2010, 19:05 Uhr
- Noch ein Link -- saibling -- 2. Februar 2010, 20:41 Uhr
- Re: Noch ein Link -- Mycelio -- 7. Februar 2010, 01:06 Uhr
Pilze Pilze Forum Archiv 2010 wird administriert von Georg Müller mit WebBBS 5.12.